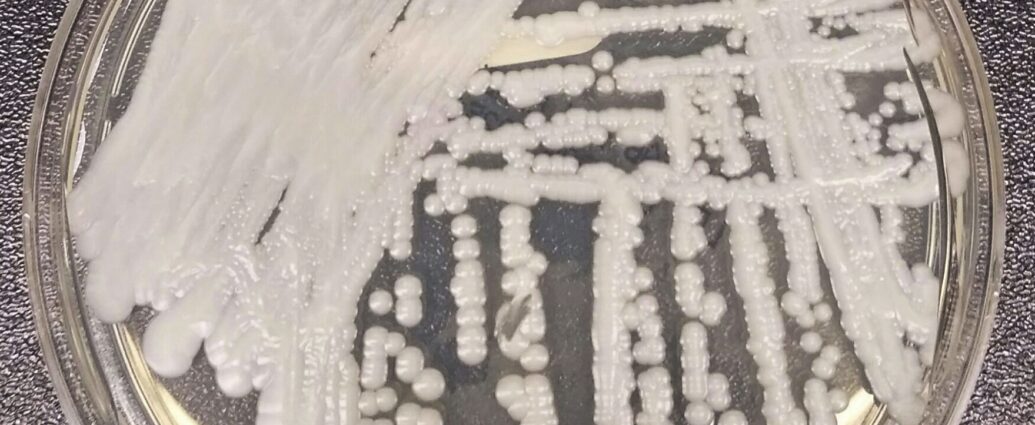

URL has been copied successfully!
They can pose a threat to human health — yeast infections are but one example. Scientists say not enough attention is paid to their ability to develop resistance to medications that treat them.
(Image credit: Shawn Lockhart)
![]()
This post was originally published here